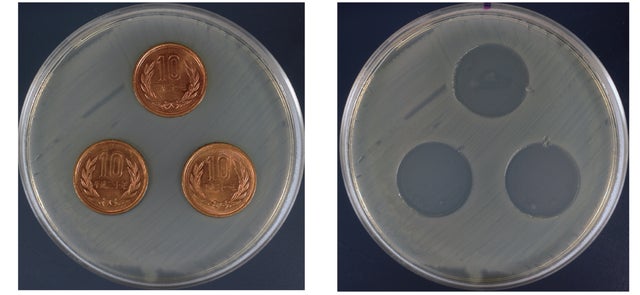

プロジェクト実行者
ストーリー
- 銅の抗菌・抗ウイルス効果に着目。手もとの安心を第一に考え「銅のマウスパッド」を作りました
- カフェ・オフィス・自宅等、どこでも使えるコンパクトでシンプルなデザイン
- 超抗菌パワーのある製品として、日本銅センター認証済。信頼のおける日本製


新しい生活スタイルに向かっていく今
■日常のウイルス対策に。
■使用頻度の高いアイテムとして。
■いつでも、どこでも、場所を選ばず。
この想いをカタチにしたい!
抗菌銅でシンプルにデザインした、銅製マウスパッドです。


「手洗い、うがい、マスク」
新しい生活スタイルの新たな習慣です。
ウイルスは至るところに存在しています。
感染経路で多いとされるのが「手」です。

日常生活において、私たちはスマホやパソコン、電車のつり革など
無意識に「手」で触れています。
「手」には、抗菌・抗ウイルスアイテムが必要です。

一般社団法人日本銅センターでは様々な実証試験を行い、銅の抗菌効果を科学的に実証しています。
【抗ウイルス試験の結果】

【抗菌効果の比較結果】

【ボールペンでの細菌汚染の実験結果】

・・・・・・・・・・・・・・・・・・・(出典元:一般社団法人日本銅センター)


パソコンに向き合う時間が増えています。
安心、安全に仕事や作業を行えるよう、
抗菌効果に優れた銅でマウスパッドを作りました。

ここでは、銅マウスパッドの4つの特徴についてご紹介します。

①抗菌・抗ウイルス
・・・ ・・・・・・・・・・・・・・・・・・・・・・・【菌の発育実験の結果】
・・・・・・・・・・・・・・・・・・。(出典元:一般社団法人日本銅センター)
私たちが使っている10円硬貨、実は銅でつくられています!
銅のもつ優れた抗菌性、抗ウイルス性で、手もとからの感染対策!
②コンパクトで持ち運びに便利

コンパクトなサイズで持ち運びにも便利。
オフィス、カフェ、自宅等、場所を選ばず、どこでも使えます。
③日本製、信頼の「CuSTAR」マーク

・・・・・・・・・・・・・ ・・・・・(出典元:一般社団法人日本銅センター)
・・・・・・・・・※「CuSTAR」マーク認証:製造元のユニ金属株式会社にて取得
④使い込むほどに味わいが増す
銅の経年変化

人の肌に触れ、空気に触れる事で少しずつ表情を変えていく銅製品。
時の移り変わりを感じ、味わいが増していきます。
使い込むほどに色の変化が出てきますが、抗菌効果に変化はございません。
【気になる方は以下の方法でお手入れができます】

◆お酢をつけたやわらかい布やスポンジで銅マウスパッドを軽くこすると
ご購入時に近い色に変化します。
※研磨剤や目の粗いスポンジ等でこすると細かな傷がつきますのでご注意ください。

オフィス・カフェ・自宅等、さまざまなシーンでお使い頂けます。



✦「銅」・「黄銅」の2種類から選べます✦
サイズ : 150mm(縦)×180mm(横) ×0.7mm(厚さ)
重さ : ・銅=169g ・ 黄銅=158g
素材 : ・銅=純銅 ・ 黄銅=銅60%+亜鉛40%
✦黄銅は別名真鍮とも言われます
製造 : 日本製
資金の使い道
銅マウスパッドの製造、マーケディング費用に使用させて頂きます。
プロジェクト実行者

Teams高島です。
私たちはお客様に本物のよい商品をお届けするために商品開発・輸入・卸売り販売の事業を展開しております。 「Teams」にはお客様や働く仲間とのつながりを大切にしたい、物を所有する喜び、様々な経験や体験をシェアしていきたい、そんな思いを込めております。
今回の銅マウスパッドが皆様の日常に少しでも安心・安全をご提供できれば幸いです。皆様のご支援、どうぞ宜しくお願い致します。
リスク&チャレンジ
※銅製品は空気に触れる事で酸化が進み色合いが変化していきますが、抗菌効果に変化はございません。経年の変化を是非お楽しみください。 ※様々なマウス方式にてテストを行いましたが、銅の光沢の兼ね合いでマウスの反応が遅い場合があります。現在反応が遅くなるマウスとして把握しておりますのはApple社のmagic mouse2で ございますので、ご購入の際にはご注意ください。 ※応援購入の数が想定数以上を上回った場合、製造工程所の都合等により出荷時期が遅れる場合がございます。 ※本プロジェクトを通して想定を上回る皆様からご支援を頂き、現在進めている環境から量産体制を更に整える事ができた場合、正規販売価格が予定価格より下回る可能性がございます。 プロジェクトに記載している内容に変更がある場合は、できるだけ早く活動レポートなどで共有を行なっていく予定です。
サポーターからの応援コメント
文章のトップに戻る
応援購入する
このプロジェクトはAll in型です。目標金額の達成に関わらず、プロジェクト終了日の2020年10月30日までに支払いを完了した時点で購入が成立します。
【先着100名様 25% OFF】 銅マウスパッド×1

3,000円(税込)
【先着100名様 25% OFF】
銅マウスパッド×1
一般販売予定価格 4,000円(税込)
お好きな色をお選びください。
※送料込みの価格となります。
※購入後の返品・カラー交換はできません。
※皆様のご支援により量産効率が向上した場合
正規販売価格が販売予定価格より下がる可能性もございます。
※デザイン・仕様は変更になる可能性もございます。ご了承ください。
※ご注文状況、使用部材の供給状況、製造工程上の都合等により 出荷時期が遅れる場合があります。
【1000個 22% OFF】 銅マウスパッド×1

3,120円(税込)
【1000個 22% OFF】
銅マウスパッド×1
一般販売予定価格 4,000円(税込)
お好きな色をお選びください。
※送料込みの価格となります。
※購入後の返品・カラー交換はできません。
※皆様のご支援により量産効率が向上した場合
正規販売価格が販売予定価格より下がる可能性もございます。
※デザイン・仕様は変更になる可能性もございます。ご了承ください。
※ご注文状況、使用部材の供給状況、製造工程上の都合等により 出荷時期が遅れる場合があります。
【先着100名様 28% OFF】 銅マウスパッド×2

5,760円(税込)
【先着100名様 28% OFF】
銅マウスパッド×2
一般販売予定価格 4,000円(税込)/1個
1個あたり2,880円なるお得なセットです。
お好きな色をお選びください。
※送料込みの価格となります。
※購入後の返品・カラー交換はできません。
※皆様のご支援により量産効率が向上した場合
正規販売価格が販売予定価格より下がる可能性もございます。
※デザイン・仕様は変更になる可能性もございます。ご了承ください。
※ご注文状況、使用部材の供給状況、製造工程上の都合等により 出荷時期が遅れる場合があります。
【限定100法人様 30% OFF】 銅マウスパッド×5

14,000円(税込)
【限定100法人様 30% OFF】
銅マウスパッド×5
一般販売予定価格 4,000円(税込)/1個
1個あたり2,800円になるお得なセットです。
お好きな1色をお選びください。
法人向けプランはお選び頂いた1色での全個数の提供となります事ご了承ください。
※送料込みの価格となります。
※購入後の返品・カラー交換はできません。
※皆様のご支援により量産効率が向上した場合
正規販売価格が販売予定価格より下がる可能性もございます。
※デザイン・仕様は変更になる可能性もございます。ご了承ください。
※ご注文状況、使用部材の供給状況、製造工程上の都合等により 出荷時期が遅れる場合があります。
【限定100法人様 30% OFF】 銅マウスパッド×10

28,000円(税込)
【限定100法人様 30% OFF】
銅マウスパッド×10
一般販売予定価格 4,000円(税込)/1個
1個あたり2,800円になるお得なセットです。
お好きな1色をお選びください。
法人向けプランはお選び頂いた1色での全個数の提供となります事ご了承ください。
※送料込みの価格となります。
※購入後の返品・カラー交換はできません。
※皆様のご支援により量産効率が向上した場合
正規販売価格が販売予定価格より下がる可能性もございます。
※デザイン・仕様は変更になる可能性もございます。ご了承ください。
※ご注文状況、使用部材の供給状況、製造工程上の都合等により 出荷時期が遅れる場合があります。
「Makuake(マクアケ)」は、実行者の想いを応援購入によって実現するアタラシイものやサービスのプラットフォームです。このページは、 プロダクトカテゴリの 「抗菌×抗ウイルス×シンプル!銅の超抗菌パワーをマウスパッドに!」プロジェクト詳細ページです。







